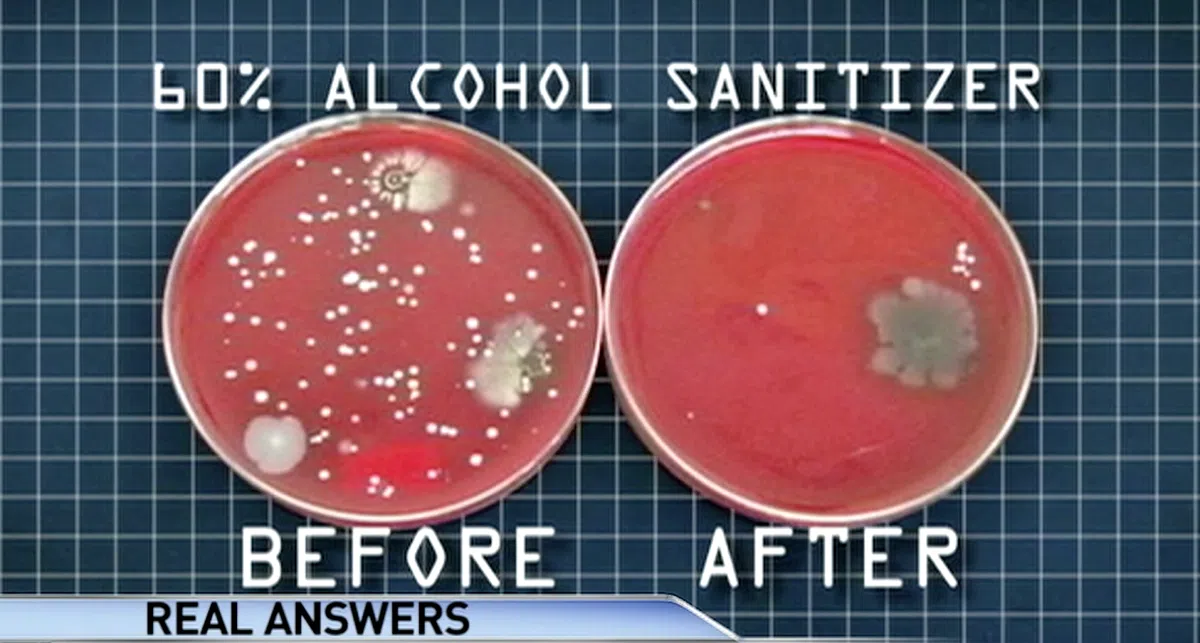
左为洗手前，右为使用60%酒精含量的免洗消毒液后。（视频截图）
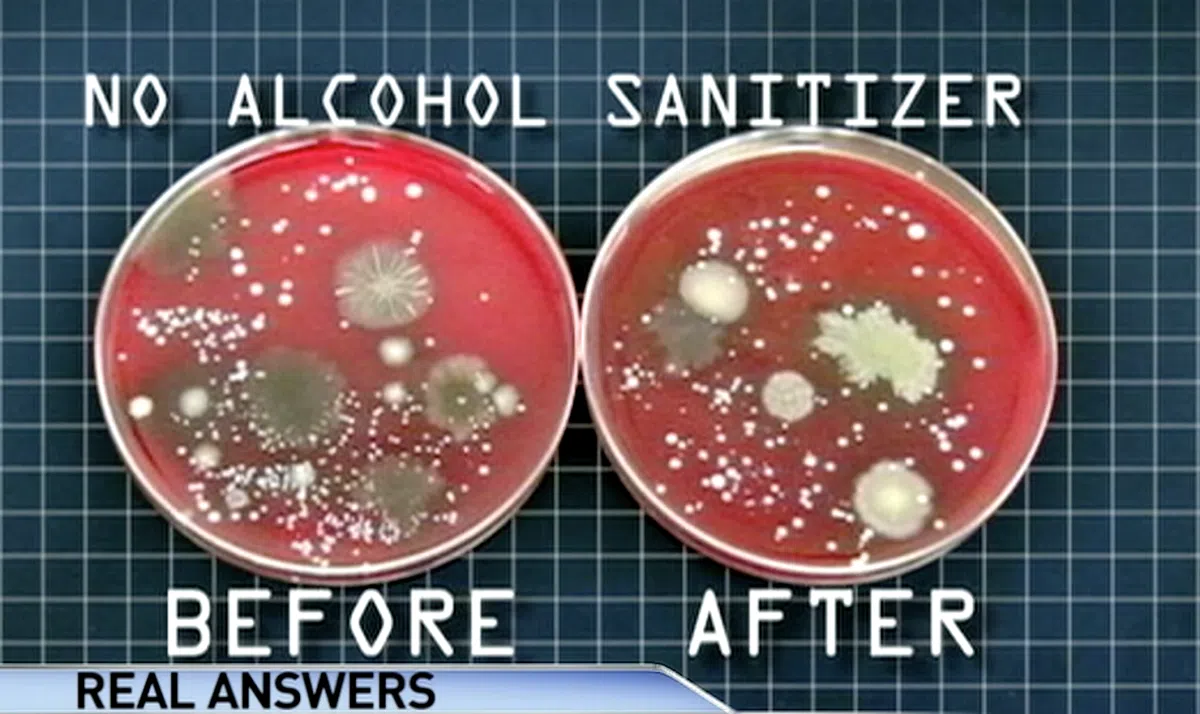
左为洗手前，右为使用0%酒精含量的免洗消毒液后。（视频截图）
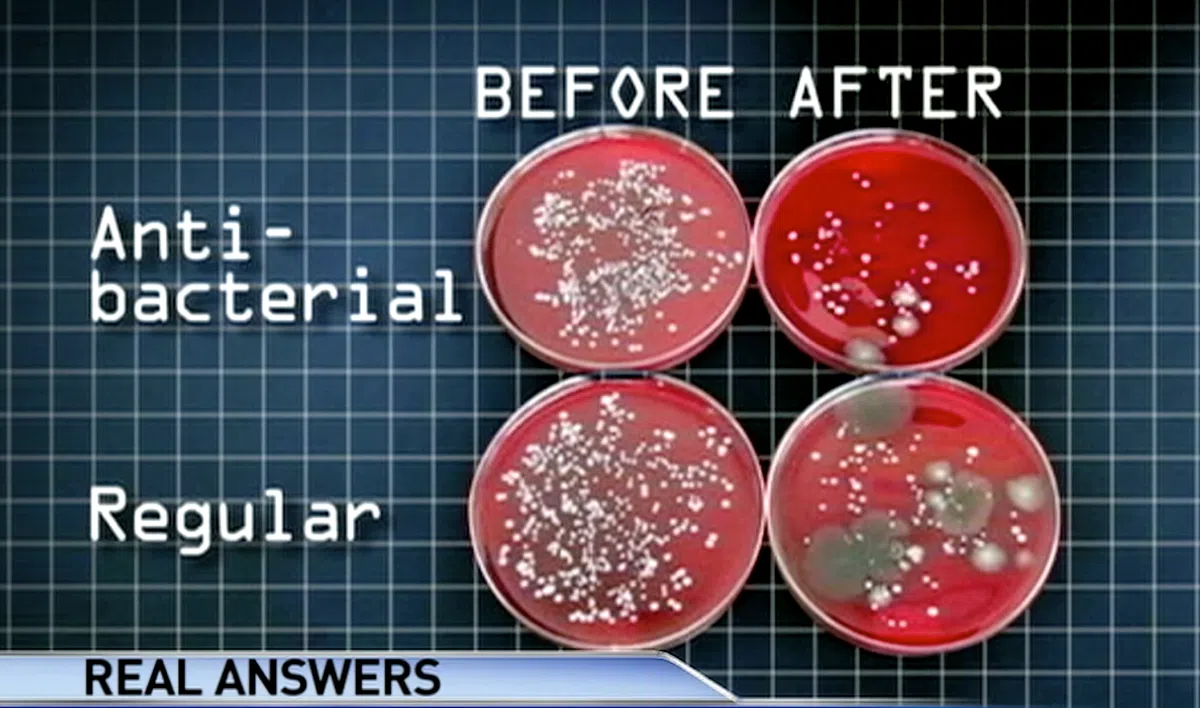
上排：杀菌肥皂。左为洗手前，右为洗手后。下排：普通肥皂。左为洗手前，右为洗手后。（视频截图）

免洗消毒液和肥皂,哪种洗手方式更有效?

含有杀菌功效的肥皂是首选
最近,身为外食族的红蚂蚁出外用餐时,随处可见食客在动筷子之前,会先从包里掏出免洗消毒液进行“干洗手”。
不少餐馆员工在带位前,都会拿着一瓶免洗消毒液往食客们的手掌上挤一挤,并解释这是为了防止食客将外面触碰到的细菌或病毒带入餐馆内。
这些现象不外乎为了对抗“2019冠状病毒疾病(简称冠病19)“,所采取的一些确保个人卫生的措施。
这两个月人们纷纷抢购消毒用品,让全球除了出现“口罩慌”,也出现了“免洗消毒液慌”。这两样原本可在各大药妆店以平价购买的物品,如今严重缺货,更有无良商家趁机以超高价格牟利。
其实,就算买不到免洗消毒液也不用慌张,就如同政府屡次呼吁国人在对抗冠病19时,用肥皂洗手才是最重要的。
这是因为勤洗手能有效减少和防止病毒依附在我们的双手,然后再触摸到眼耳鼻。
肥皂洗手能有效清除细菌
去年12月,一名美国小学教师Jaralee Annice Metcalf,在她的面簿上分享了一项她在课堂上做的科学小实验。
她从同一条面包中随机抽取五片面包。五片中只有一片没被污染的,用作对照用途。其余的4片面包分别被手提电脑、以温水与肥皂清洗过的手、用免洗消毒洗手液清洗过的手以及肮脏的手触碰过。
这些面包随后被放入密封袋中观察约4个星期。
实验结果出炉:


从实验结果中能看到,就算已经用免洗消毒液清洗过的双手,双手还是带有细菌,导致面包出现少部分的发霉。
相反的,用了肥皂和温水清洗过的手,相当干净几乎没有细菌,因而面包几乎没有受污染。从外观上来看,它和没被污染的面包没两样。
Jaralee 在帖文中也表示,他们使用的就是一块很普通的肥皂,包装上甚至没标注“抗菌”等字眼。而且,所有同学都根据实验要求,摸过那些需要被触碰的面包。
因此,她在帖文中也再次呼吁人们应该常洗手,尤其是常常生病的人们更应该勤洗手来避免自己受到细菌感染。
要懂得如何挑选免洗消毒液
看到这里,相信不少蚁粉心里一定在想:
难道那些免洗消毒液瓶包装上主打的“杀菌率99.9%”等标语都是骗人的?
那也不尽然。
美国疾病管制与预防中心(CDC)指出,
如果在没有肥皂和水的情况下,起码要使用含有至少60%酒精的免洗洗手液。
这里的重点是消毒液所含的酒精成分,因为只有60%以上的酒精成分才能在短时间内清除一定数量的细菌。
澳洲新闻台ABC News也曾做过一项关于免洗消毒液的实验。科学家让参与实验的人们使用含有60%的消毒液和无酒精消毒液来进行对比。

随后,科学家在确保他们手上的消毒液完全干透后,要求他们将手印在琼脂平板(Agar Plate)上。
琼脂平板是一种把消毒后的培养基加上繁殖微生物所需材料后制成的有盖培养皿。
结果如下:

澳洲新闻台也做了另外一组对比杀菌肥皂和普通肥皂的杀菌功效的实验。
有图有真相!蚁粉现在知道要用有杀菌功效的肥皂洗手最干净。
有兴趣的蚁粉可点击?视频观看完整实验:
另外,很多人生怕洗不干净,所以按出大量免洗消毒液在手上,洗的时候使劲揉搓。事实上,这样的深度清洁会损伤皮肤,使皮肤不但留不住水分,还更容易让病菌侵入。
CDC建议,使用免洗消毒液时应按照包装上的正确使用量,并将消毒液搓至干透为止。
有效洗手学问可不少
不少人会心想,洗手嘛,这从小做到大的事情,有谁不会?
别以为用清水和肥皂搓两下就好了,要是没跟着正确的步骤洗手,那就相当于白洗了!
要是想做到有效洗手,CDC建议洗手的时间最少要20秒,并且应跟着以下的八步骤:

赶快把这个“洗手宝典”贴在你家的洗手盆前,或者直接把它设为手机屏幕,随时拿出来参照。
至于为什么要20秒以上呢?这是因为多数人都只会对手掌进行清洗,往往忽略了指缝和指甲缝,从而达不到最佳的杀菌效果。
不少卫生组织也建议用流动水洗手,若手上沾有明显污渍时使用肥皂进行清洗,更有效杀菌。
保持个人卫生,人人有责。在这对抗病毒的期间,让我们在卫生道路上更加尽责,防止病毒的快速传播。